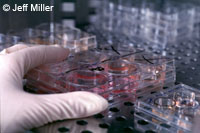

Réactions mitigées à l'accord de l'UE sur les cellules souches
Même si l'accord obtenu, lors du Conseil Compétitivité, en matière de recherche sur les cellules souches engage seulement l'Union européenne à faire ce qu'elle a fait jusqu'ici, son annonce a néanmoins suscité de vives réactions émanant des lobbys partisans ainsi qu'adversaires de la recherche sur les cellules souches. L'industrie s'est félicitée de cet accord qui autorise une recherche restreinte basée sur des cellules souches embryonnaires humaines, mais pas la destruction des embryons pour la culture de lignées de cellules souches. La recherche qui implique le clonage humain à des fins reproductives, la recherche visant à modifier le patrimoine génétique d'êtres humains qui pourrait rendre ces changements héréditaires et la recherche visant à créer des embryons humains uniquement à des fins de recherche ou d'approvisionnement en cellules souches ne bénéficiera pas d'un financement. EuropaBio, l'association européenne des bioindustries, a salué cet accord, déclarant: "Poursuivre le financement de la recherche sur les cellules souches embryonnaires au niveau européen est un signal positif pour la recherche européenne dans le domaine des biotechnologies qui, un jour, pourrait offrir de l'espoir aux patients atteints de pathologies telles que les maladies de Parkinson ou d'Alzheimer." Le ministre britannique de la science, lord Sainsbury, a également considéré cet accord comme étant un progrès qui représente bien l'Europe. "En Europe, nous avançons sur ce front alors que les Etats-Unis ont adopté une position très négative, du moins en ce qui concerne le gouvernement fédéral. Il est extrêmement positif que l'Europe aille de l'avant." Le 19 juillet dernier, le président américain, George W. Bush, a opposé son veto à un projet de loi qui aurait levé les restrictions existantes sur le financement fédéral sur la recherche basée sur les lignées de cellules souches embryonnaires, ainsi que sur la création de nouvelles lignées cellulaires à partir d'embryons congelés considérés comme excédentaires dans les cliniques spécialisées dans le traitement de la fertilité. Toutefois, le compromis dégagé lors du Conseil Compétitivité du 24 juillet a fait l'objet de critiques: ses détracteurs lui reprochent de ne pas aller assez loin et de franchir certaines barrières éthiques. Le célèbre scientifique britannique Stephen Hawking a déclaré que cette décision était "frileuse". "Si j'ai bien compris, tant que la création de nouvelles lignées de cellules souches est financée sur des fonds privés ou des budgets nationaux, les fonds communautaires pourront être affectés à la recherche utilisant ces lignées. Nous éliminons de nombreux embryons dans le cadre de la FIV et personne n'émet d'objection. Ne serait-il pas préférable d'utiliser quelques embryons afin de sauver des vies?", a-t-il déclaré à EducationGuardian.co.uk. Le Vatican est opposé à la recherche impliquant des cellules souches et le journal du Vatican L'Osservatore Romano a qualifié l'accord de "produit macabre d'un sens tordu du progrès." Les fidèles de l'Eglise catholique romaine estiment que la vie commence dès la conception. Un fonctionnaire du Vatican en charge des questions bioéthiques, Monsignor Elio Sgreccia, a qualifié la décision de "grave" et a déclaré qu'elle autorise "le recours à des êtres humains sur la base suivante: "je te tue afin d'obtenir des avantages pour d'autres". Alors que le Parlement européen a suspendu ses travaux pour l'été, il n'y a pas encore d'indication quant à l'avis des eurodéputés sur cet accord, mais tout cela se précisera lorsque la proposition sur le 7e programme-cadre passera en deuxième lecture au Parlement cet automne.